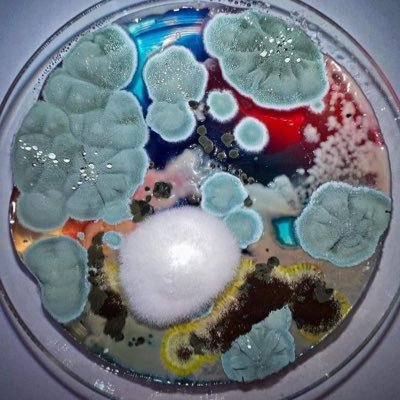

قد يعجبك
Będę dziś świadkiem końca świata… W „Wierszalin. Reportaż o końcu świata” w @TeatrWierszalin zagłębiam się w historię Eljasza Klimowicza – samozwańczego proroka z Podlasia, który łączył wiarę z lękiem i nadzieją. Wpadnijcie zobaczyć, jak ten świat ożywa na scenie! #teatr #aktor
Aktorstwo to coś więcej niż sztuka. Steven Brown twierdzi, że zdolność do wcielania się w role była kluczowa dla ludzkiej ewolucji. Najpierw naśladowanie. Potem pantomima. Potem historie. W końcu – TEATR. Dzięki temu zbudowaliśmy wspólnoty, kulturę i komunikację. #EveryActor
🧠 Psychologia uczy nas rozumieć ludzi, aktorstwo – czuć ich emocje. 🎭 Jedno analizuje, drugie przeżywa. Ale czy naprawdę da się oddzielić rozumienie od przeżywania? Dziś #DzieńPsychologa – święto tych, którzy odkrywają mechanizmy ludzkiej duszy. #Psychologia #Aktorstwo
🎭 „Pierwsza próba za nami! Emocje, energia i pierwsze poszukiwania. Książka, którą nagrodziliśmy na festiwalu #MiędzyWierszami, zaczyna żyć własnym scenicznym rytmem. To będzie piękna podróż! #NowySpektakl”

Reżyserowanie spektaklu to jak układanie puzzli bez obrazka. Ale kiedy słowo staje się ciałem… magia się dzieje. #TeatrWierszalin #TeatrKtóryŚpiewa
10 lat w roli profesora Konstantego, a spektakl „Wziołowstąpienie" wciąż żyje i zachwyca nowych widzów. Kto widział?”

Zapraszamy na spotkanie online w rocznicę aresztowania ANDŻELIKI BORYS i ANDRZEJA POCZOBUTA facebook.com/events/1141748…

Szpaki nad Rzymem!
"Dzień Gniewu" z 6 nominacjami International Christian Film Festival w Orlando na Florydzie Best Picture Most Inspirational Feature Film Best Director (Jacek Raginis) Best Lead Actor (Radek Pazura) Best Supporting Actor (Rafał Gąsowski) Best Supporting Actor (J. Marczewski)

Miesięczna podróż i rezydencja artystyczna w Nowym Jorku lub Wilnie jest na wyciągnięcie ręki! Wystarczy spróbować swoich sił w konkursie Artystyczna Podróż Hestii. Nabór zgłoszeń trwa do 23 marca. @ERGO_Hestia @MSN_Warszawa @NCK_PL @MKiDN_GOV_PL nck.pl/patronaty/patr…
nck.pl
Wystartowała 20. edycja konkursu Artystyczna Podróż Hestii | Narodowe Centrum Kultury
Do udziału w konkursie zapraszamy studentw i studentki IV i V roku studiw jednolitych, oraz I i II roku studiw magisterskich uczelni artystycznych, tworzących prace w obszarach: malarstwa, grafiki,
Nagród Ci u nas dostatek, ale przyjmiemy i ten „Złoty Ryngraf”!” 🏆💪 „Dziady” zwycięzcą festiwalu "Pamięć i Tożsamość”❗️ Z tej okazji wyjątkowy wieczór w @TVP_Kultura, bo o g.20.00 obie części „Dziadów”. Świętujcie z Teatr Wierszalin ! 🍾😄
Sypnęło na koniec lutego… nagrodami w Wirginii w USA! 🏆🇺🇸 A m.in. BEST SUPORTING ACTOR (Rafał Gąsowski), BEST VILLAIN (Rafał Gąsowski)🎉 Dziękuję za gratulacje, wsparcie i gratuluję wszystkim nagrodzonym! 💞
Miesięczna podróż i rezydencja artystyczna w Nowym Jorku lub Wilnie jest na wyciągnięcie ręki! Wystarczy spróbować swoich sił w konkursie Artystyczna Podróż Hestii. Nabór zgłoszeń trwa do 23 marca. @ERGO_Hestia @MSN_Warszawa @NCK_PL @MKiDN_GOV_PL nck.pl/patronaty/patr…
nck.pl
Wystartowała 20. edycja konkursu Artystyczna Podróż Hestii | Narodowe Centrum Kultury
Do udziału w konkursie zapraszamy studentw i studentki IV i V roku studiw jednolitych, oraz I i II roku studiw magisterskich uczelni artystycznych, tworzących prace w obszarach: malarstwa, grafiki,
“No artist is ahead of his time. He is his time, it’s just that others are behind the times.” — Martha Graham #MondayInspiration 📸 Barbara Morgan

Przekornie nazwałem to "piątką Gąsowskiego" czyli... pięć przedstawień, które trzeba i można zobaczyć 😊 Więcej tu: rafalgasowski.pl/blog/2021/01/1… fot. M. Rybij instagram.com/p/CKlQ_WrHYBA/…
United States الاتجاهات
- 1. Baker 30.1K posts
- 2. Cowboys 72.6K posts
- 3. 49ers 31.3K posts
- 4. Fred Warner 10.4K posts
- 5. Packers 27.6K posts
- 6. Panthers 73.8K posts
- 7. Bucs 9,424 posts
- 8. Tez Johnson 2,758 posts
- 9. Niners 4,928 posts
- 10. Zac Taylor 2,803 posts
- 11. #FTTB 3,940 posts
- 12. Titans 22.6K posts
- 13. Browns 64.8K posts
- 14. Cam Ward 2,259 posts
- 15. Yoshi 33.1K posts
- 16. Ravens 64.3K posts
- 17. Dolphins 46.7K posts
- 18. #Bengals 2,846 posts
- 19. #GoPackGo 3,423 posts
- 20. Geno Smith 2,101 posts
قد يعجبك
-
 Agua y Saneamiento en Latinoamérica Rural
Agua y Saneamiento en Latinoamérica Rural
@LatinWASH -
 viviean ⓥ 🌱
viviean ⓥ 🌱
@Valentinech043 -
 Marcin Tymków
Marcin Tymków
@MarcinTymkow -
 Teatr Witkacy
Teatr Witkacy
@WitkacyTeatr -
 Claire Parker 🌸🦋🪻
Claire Parker 🌸🦋🪻
@Clairflowerpunk -
 Ludo Palpatoche 🔻
Ludo Palpatoche 🔻
@LudoPalpatoche -
 Adam Gehrke
Adam Gehrke
@gerksgunner -
 LJVegan
LJVegan
@LGleason3 -
 StroudSzn
StroudSzn
@FieldsOfJustin_ -
 Matt McGain
Matt McGain
@McgainMatt
Something went wrong.
Something went wrong.